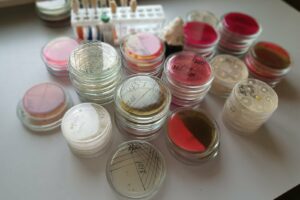

Хоча приватні кабінети стають дедалі популярнішими, Чортківська міська стоматологічна поліклініка щороку підтверджує свій статус якісного та доступного закладу. Окрім помірних цін для людей, поліклініка надає повністю безкоштовні послуги нашим захисникам – як діючим військовослужбовцям, так і ветеранам війни. І не тільки їм! Про це далі – детальніше.
Як розповіла керівниця Чортківської міської стоматологічної поліклініки Марія Антонюк, у рамках Програми медичних гарантій НСЗУ у ...
На виконання ст.25 Закону України « Про основні принципи та вимоги до безпечності та якості харчових продуктів» Чортківським районним управлінням Головного управління Держпродспоживслужби в Тернопільській області проводиться державна реєстрація потужностей, які використовуються на будь-якій стадії виробництва та обігу харчових продуктів. Державній реєстрації підлягає кожна окрема потужність оператора ринку, яка проводиться на основі поданої заяви про реєстрацію такої потужності у ...
Родини безвісти зниклих військовослужбовців та особи з інвалідністю І–ІІ групи, отриманою внаслідок війни, можуть отримати продуктові набори.
Для отримання допомоги просимо представників зазначених категорій у четвер, 9 квітня, звернутися до кабінету №26 Чортківської міської ради.
При собі необхідно мати:
паспорт;
посвідчення (для осіб з інвалідністю внаслідок війни);
сповіщення (для родин безвісти зниклих).
Управління соціального захисту та охорони здоров’я Чортківської міської ради інформує про проведення відкритих торгів з визначення підрядних організацій для реалізації двох масштабних проєктів на базі Чортківської центральної міської лікарні.
Обидва проєкти є стратегічно важливими для розвитку нашої кластерної лікарні. Зазначимо, що їх реалізація відбуватиметься за кошти місцевого та державного бюджетів.
№ «Капітальний ремонт приймально-діагностичного відділення та відділення ...
Багато чортків’ян прийшли до подвір’я Собору верховних апостолів Петра і Павла провести в останню життєву дорогу ще зовсім молодого хлопця, чортків’янина, 24-річного воїна Куропатву Миксима (14.05.2001 р.н.).
Максим після закінчення 9 класів у Чортківській гімназії №3 ім. Романа Ільяшенка (теперішня назва закладу), вступив та закінчив Чортківське вище професійне училище, здобувши професію маляра-штукатура.
Але велика війна, яка ступила на українську землю широкою лінією фронту, ...